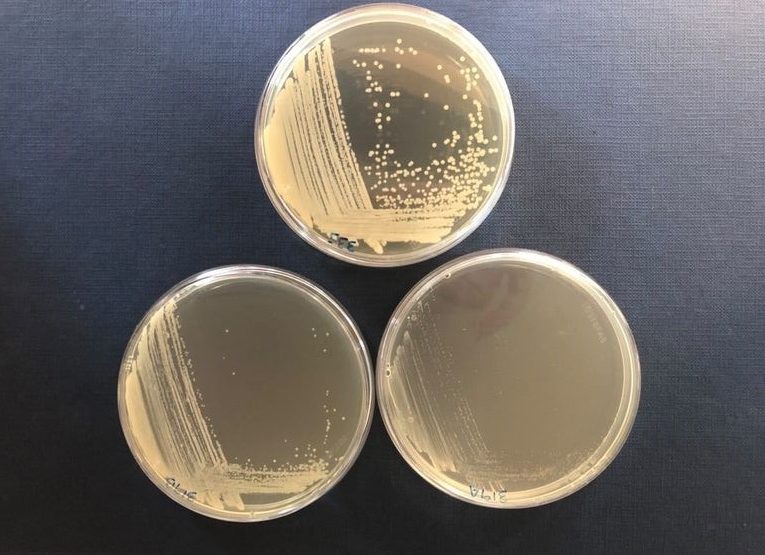

Acinetobacter – a bactéria hospitalar que está a causar infeções graves nos pacientes
- 13/01/2022
- Atualidade Saúde
[Texto de Diana Morais Ferreira]
Acinetobacter é uma bactéria hospitalar que tem causado infeções graves nos pacientes e que terá sido encontrada em produtos alimentares.
Com base numa investigação de mestrado em Microbiologia Aplicada de Catarina Ferreira, estudante da Universidade Católica Portuguesa, está a ser desenvolvido um projeto sobre uma bactéria – Acinetobacter spp. –, cuja presença foi já identificada a nível hospitalar e clínico, e ainda em alimentos. Catarina Ferreira tem como objetivo investigar a capacidade de infeção via alimentar.
Segundo a investigação, Implicações de Acinetobacter spp. em doenças de origem alimentar, de Catarina Ferreira, terá sido registada a incidência da bactéria – Acinetobacter spp. – a nível hospitalar e clínico, e ainda que terá sido registado um aumento significativo da sua presença.
Acinetobacter spp., são bactérias que se encontram amplamente distribuídas pelo ambiente e que estão presentes em variados locais, tais como, o solo, a água, os esgotos, etc., sendo que algumas espécies são mais associadas a uns locais do que a outros.
Com base no estudo, esta bactéria é responsável por inúmeras infeções graves nos pacientes, sobretudo naqueles que necessitem de oxigénio, da utilização de cateteres ou outros recursos que impliquem a introdução de tubos através da pele. “Além disso, sendo estes microrganismos multi-resistentes, isto é, apresentam resistência a um grande grupo de antibióticos vulgarmente utilizados no combate às infeções, torna-se de extrema importância conhecer todos os reservatórios das acinetobactérias para que seja possível controlar/evitar as infeções das mesmas”, explica Catarina Ferreira.
De acordo com anteriores investigações, já terá sido encontrada a presença desta bactéria em produtos alimentares, tais como, os lácteos, as carnes e os vegetais, e isto significa que poderá constituir um patogénico alimentar. Ou seja, pode constituir um microrganismo capaz de provocar infeções alimentares em caso de ingestão de alimentos contaminados.
O estudo aponta ainda que nos casos de infeção alimentar por Acinetobacter spp. não se registaram sintomas como a diarreia e os vómitos, o que torna mais difícil de detetar, “uma vez que vulgarmente não se associa “a algo que se comeu e fez mal”, explica Catarina Ferreira.
O intuito deste projeto é investigar a capacidade de infeção via alimentar e, desta forma, começaram por identificar todas as amostras disponíveis através de métodos de biologia molecular. Seguidamente escolheram uma matriz alimentar – carne de peru picada – para testar e foram simuladas as condições do trato intestinal (condições das várias fases da digestão de um alimento) assim como testaram a capacidade de resistência dos vários isolados às mesmas. Já numa fase final do processo, através da cultura celular, testaram a capacidade das várias espécies de acinetobacterias aderirem e invadirem as células intestinais para perceberem se, mesmo resistindo às condições da digestão, têm ainda capacidade de “entrar” nas células do intestino e causar infeção.
Doenças alimentares são um problema cada vez mais atual
Cada vez mais se expandem as doenças alimentares em todo o mundo e isto deve-se a fatores como: o aumento e envelhecimento da população, a pobreza e o aumento de idosos em centros de dia. “Havendo um surto de origem alimentar, afeta automaticamente um maior número de pessoas”, explica a bióloga Catarina Ferreira.
Os fatores tecnológicos também são um explicativo deste fenómeno, tais como: a exigência do consumidor, a manipulação pela qual passam os alimentos e a capacidade do sistema de identificar uma doença de origem alimentar. A bióloga ainda evidencia outros fatores como as novas dietas que pressupõem a redução de frutas e vegetais, a importação de alimentos de diversos lugares, fatores climáticos e a contaminação dos solos e das águas, acrescenta ainda “e a emergência de organismos patogénicos, isto é, o reaparecimento de microrganismos mais evoluídos ou resistente a antibióticos, o que dificulta o seu combate e podem causar maior severidade da doença associada”.
De acordo com Catarina Ferreira, as infeções alimentares são diferentes de intoxicações alimentares. “As infeções são causadas pela ingestão de um alimento contaminado por um microrganismo, que invade e se multiplica no hospedeiro, neste caso o Homem. No fundo, reproduz-se no corpo humano, causando sintomatologia. Já as intoxicações são causadas pela ingestão da toxina proveniente da bactéria. Ou seja, acontece com bactérias que têm a capacidade de produzir um composto tóxico capaz de causar reação ao Homem.” Acrescenta ainda que nas intoxicações os sintomas são mais rápidos, aparecendo em poucas horas, “em alguns casos 2h são suficientes”. Ao contrário destas, explica que as infeções demoram mais tempo, uma vez que o microrganismo tem de se multiplicar até causar sintomatologia, “às vezes surgem passados vários dias”.
| Sintomas de infeção pela bactéria Acinetobacter spp. Os sintomas de infeção pela bactéria Acinetobacter variam de acordo com o lugar onde se desenvolve, sendo que, normalmente aloja-se na corrente sanguínea. Febres altas, náuseas, tonturas e diminuição da pressão arterial são sintomas comuns da infeção na corrente sanguínea. Dificuldades respiratórias, dores no peino e infeções urinárias são também sintomas possíveis quando a bactéria se encontra no sistema respiratório ou no sistema urinário. |
